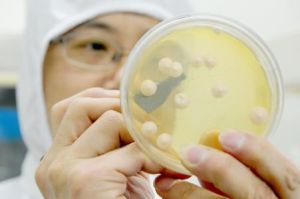
營養生物 營養生物

地址
營養生物造就良性生態系統。只要施用恰當,它就會與所到之處的良性力量迅速結合,產生抗氧化物質,清除氧化物質,消除腐敗,抑制病原菌,形成良好的生態環境,同時,它還產生大量易於吸收的有益物質,如胺基酸、有機酸、多糖類、各種維生素、各種生化酶、促生長因子、抗生素和抗病毒物質等,提高動植物的免疫功能,促進健康生長,從而在減輕勞動、降低成本、提高產量、改善品質,提前上市,使人們在吃(用)上無污染的高質量產品的前提下,提高全社會的生產水平和生活質量,保護地球環境和人類美好的家園。營養生物原液以其無毒副作用、無耐藥性、無殘留、成本低,且保健、防疫、促生長的效果十分顯著等特點,全面改善農副產品的品質,達到無公害綠色產品標準,具有顯著的環保效益、經濟效益和社會效益。
介紹
生物營養學(又稱生理營養學)是利用化學和物理化學方法在分子水平上研究有機體的生命現象,即研究分子結構、動植物細胞和細菌細胞的化學變化和物理化學變化,並分析它們的調節和組織。首先是物質交換、食物的分解、向化學能轉化並成為細胞物質構成一部分的過程。 進一步的研究對象包括催化作用因子,酶(酶科學)及分子信息載體、核糖核酸和脫氧核糖核酸(分子遺傳學、基因工程學、生物外科)。這些研究對生物學、化學、醫學、物理學的各個領域特別是對生物技術領域有著重大意義。 學習生物營養學可以通過多種渠道。在一些綜合性大學中有獨立的專業,在另外一些高校中生物化學是作為化學和生物學專業中的重點課程設定的。人類生物學專業也是以生物營養學為導向的。在藥物學、食品技術、營養學等其他學科中,生物營養學也是一門基礎性的專業。